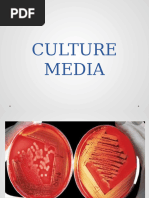

0% found this document useful (0 votes)
21 views11 pagesMycoplasma Detection
The document recommends media for detecting various mycoplasmas and provides recipes for making the recommended media. It lists liquid and solid media for detecting Mycoplasma gallisepticum, Mycoplasma synoviae, and non-avian mycoplasmas. The recipes include ingredients and instructions for making beef heart infusion broth, essential vitamins, and other components.
Uploaded by
Farzana HossainCopyright
© © All Rights Reserved
We take content rights seriously. If you suspect this is your content, claim it here.
Available Formats
Download as DOCX, PDF, TXT or read online on Scribd
0% found this document useful (0 votes)
21 views11 pagesMycoplasma Detection
The document recommends media for detecting various mycoplasmas and provides recipes for making the recommended media. It lists liquid and solid media for detecting Mycoplasma gallisepticum, Mycoplasma synoviae, and non-avian mycoplasmas. The recipes include ingredients and instructions for making beef heart infusion broth, essential vitamins, and other components.
Uploaded by
Farzana HossainCopyright
© © All Rights Reserved
We take content rights seriously. If you suspect this is your content, claim it here.
Available Formats
Download as DOCX, PDF, TXT or read online on Scribd
/ 11